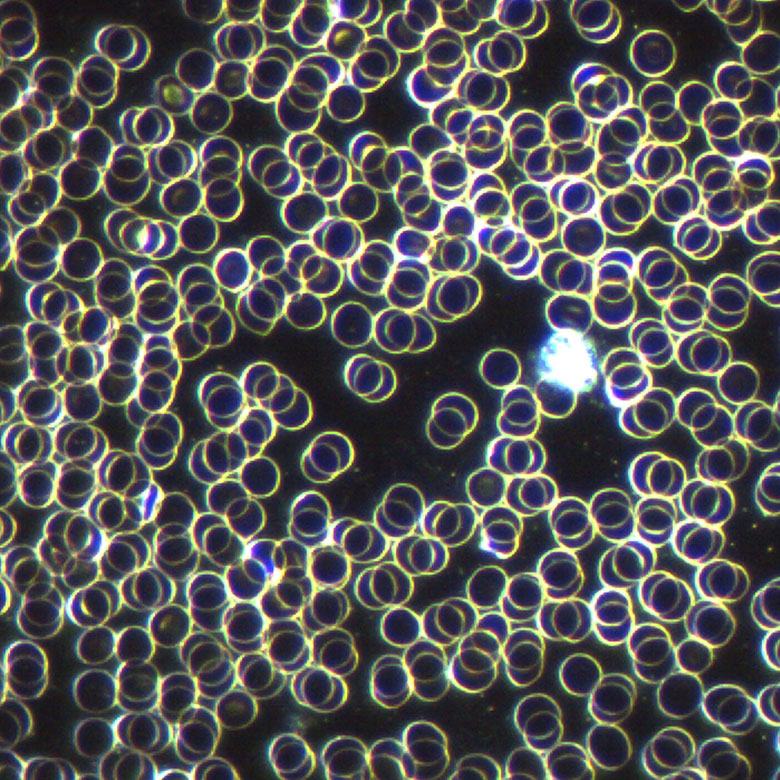
Hund Gesundheit Dunkelfeld

Gesundheit beeinflusst Verhalten
✓ Sammle Komplimente für deinen gesunden und fitten Hund
✓ Profitiere von meinen Tipps und Anregungen zum Thema Gesundheit
✓ Nutze die Möglichkeit für Gesundheitschecks für deinen Hund
Besonders körperliches Unwohlsein deines Hundes kann sein Verhalten beeinträchtigen.
Dahinter können sich viele Ursachen verbergen.
Ich gebe dir drei fantastische Möglichkeiten:
Ernährungsberatung

Ich zeige dir und kläre auf,
wie du deinen Hund gesund
ernähren kannst.
Blutanalyse
Du möchtest einen Einblick
in die Lebensuhr deines
Hundes?
Lichttherapie

Gesund und fit bis ins hohe Alter.
Sanft und schmerzfrei
therapieren.
Hier einige Bilder meiner erfolgreichen Begleitung mit den Besitzern…
Bilder links: vorher
Bilder rechts: erfolgreicher Abschluss





